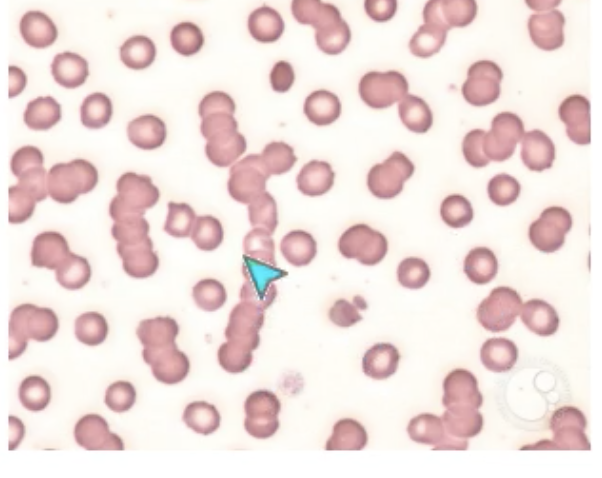

Multiple myeloma is a malignancy of the bone marrow in specifically which cells?
1 - T cells
2 - plasma cells
3 - monocytes
4 - natural killer cells
2 - plasma cells
- develop from B cells become clones with a specific antibody
- they produce an abnormal immunoglobulin called a PARAPROTEIN

In a healthy patient, do plasma cells secrete antibodies or paraprotein?
- antibodies
- paraprotein produced by abnormal B cells = monoclonal immunoglobulin or light chain present in the blood or urine
What is the incidence of multiple myeloma?
1 - 5 / 1,000,000
2 - 5 / 100,000
3 - 5 / 10,000
4 - 5 / 1000
2 - 5 / 100,000
What age is most affected by multiple myeloma?
1 - <18 y/o
2 - 20-30 y/o
3 - 40-50 y/o
4 - 60-70 y/o
4 - 60-70 y/o
- increases with age
- africans have slightly higher risk that caucasians
Is multiple myeloma currently curable?
- no
Although the exact cause of multiple myeloma is unknown, there are risk factors. Which of the following is a risk factor for multiple myeloma?
1 - family history (1st degree relative)
2 - increasing age
3 - increased oncogenes
4 - exposure to toxins
5 - all of the above
5 - all of the above
Multiple myeloma is a malignancy of the bone marrow, specifically plasma cells. In addition to secreting an abnormal immunoglobulin, they can also secrete what else?
1 - abnormal light chains
2 - abnormal heavy chains
3 - abnormal disulphide bond
4 - abnormal constant region
1 - abnormal light chains
- important for specific antigen binding
- can also have different subtypes including kappa and lamba light chains or different immunoglobulins (IgA, IgG etc..)

Multiple myeloma is a malignancy of the bone marrow, specifically plasma cells. They can be categorised into the type of immunoglobulin, kappa or lamba that is affected. Which of the following is the most common?
1 - IgA
2 - IgG
3 - IgM
4 - IgD
5 - IgE
2 - IgG
- IgG accounts for 2/3 of all cases
- IgA is next most common
Multiple myeloma is a malignancy of the bone marrow, specifically plasma cells. Which of the following tissues is NOT typically affected in multiple myeloma?
1 - blood
2 - spleen
3 - heart
4 - bone
3 - heart
Multiple myeloma is most common in older adults as it has a slow insidious onset, when typically end organ damage becomes symptomatic. This can be remember using the mnemonic CRABBI. What does the C stand for?
1 - carpal tunnel syndrome
2 - cardiac failure
3 - calcium is elevated
4 - all of the above
3 - calcium is elevated
- hypercalcaemia
- increased reabsorption of bone, suggests more serious disease
- remember Bones, Groans, Stones and Psychotic Undertones
Multiple myeloma is most common in older adults as it has a slow insidious onset, when typically end organ damage becomes symptomatic. This can be remember using the mnemonic CRABBI. What does the R stand for?
1 - renal insufficiency
2 - retinopathy
3 - reflex hypotonia
4 - all of the above
1 - renal insufficiency
Myriad of causes:
- hypercalcaemia
- infections (low WBC variability)
- dehydration (high Ca2+)
- medications due to bone pain
- type 3 hypersensitivity caused by deposition of immunoglobulins in renal tubules
Multiple myeloma is most common in older adults as it has a slow insidious onset, when typically end organ damage becomes symptomatic. This can be remember using the mnemonic CRABBI. What does the A stand for?
1 - adrenal insufficiency
2 - anaemia
3 - adenoma
4 - all of the above
2 - anaemia
- RBC production is reduced due to overproduction of paraprotein
Multiple myeloma is most common in older adults as it has a slow insidious onset, when typically end organ damage becomes symptomatic. This can be remember using the mnemonic CRABBI. What does the B stand for?
1 - breasts
2 - brain
3 - bones
4 - all of the above
3 - bones
- malignancy causes bone destruction
- lesions are common
- collapse vertebrae can cause life threatening cord compression
Multiple myeloma is most common in older adults as it has a slow insidious onset, when typically end organ damage becomes symptomatic. This can be remember using the mnemonic CRABBI. What does the second B stand for?
1 - bleeding
2 - brain infilitrates
3 - B symptoms
4 - all of the above
1 - bleeding
Bone marrow crowding results in thrombocytopenia, increasing the risk of bleeding and bruising
Multiple myeloma is most common in older adults as it has a slow insidious onset, when typically end organ damage becomes symptomatic. This can be remember using the mnemonic CRABBI. What does the I stand for?
1 - infarcts
2 - impetigo
3 - infection
4 - all of the above
3 - infection
Reduced production of normal immunoglobulins results in increased susceptibility to infection
When we try to diagnose myeloma we can do a FBC. Which of the following would NOT be commonly observed?
1 - microcytic anaemia
2 - rouleux
3 - raised erythrocyte sedimentation rate
4 - normocytic, normochromic anaemia
1 - microcytic anaemia
Iron, folate and B12 would all be fine
RBCs are crowded out due to B cells
- rouleux = lots of proteins in the blood causing RBCs to stick together which can be seen on histology
When we try to diagnose myeloma, which 2 of the following would be elevated?
1 - creatinine
2 - bilirubin
3 - urea
4 - neutrophils
1 - creatinine
3 - urea
- kidneys are heavily affected by multiple myeloma
When we try to diagnose myeloma, we can see an elevated Ca2+ due to bone breakdown due to the malignancy. Do we also see a raised alkaline phosphatase (ALP)?
- no
- ALP = would be expected to be high due to bone breakdown, but not the case
In multiple myeloma would we expect to see a raised or reduced beta 2 myoglobulin?
- raised
- tumour marker for multiple myeloma
In multiple myeloma would we expect to see a raised or reduced immunoglobulin level?
- reduced
- abnormal plasma cells are busy making paraprotein
In the blood we would expect to see raised concentrations of monoclonal IgA/IgG proteins will be present in the serum. In the urine the IgA/IgG proteins are called Bence Jones. What is the most common protein that causes Bence Jones proteins?
1 - free kappa chain
2 - free lamba chain
3 - free Ig light chain
4 - free heavy chains
3 - free Ig light chain
If a patient presents with hypercalcaemia they need to be treated as this is a medical emergency can can cause cardiac arrhythmias including torsade de pointes and ventricular tachycardia. Which of the following would patients NOT be treated with in this instance to manage the hypercalcaemia?
1 - bisphosphonates
2 - fluids
3 - dexamethasone (steroid)
4 - gentamicin
4 - gentamicin
- bisphosphonates = help rebuild bone and absorb Ca2+ (Alendronic acid, Disodium pamidronate, Zoledronic acid) BUT INCREASED RISK OF JAW OSTEONECROSIS
Steroids can destroy myeloma cells
Fluids help dilute the Ca2+ and renal function
What test can be performed to identify monoclonal antibodies, also known as M proteins in multiple myeloma (MM)?
1 - blood smear
2 - genetic testing
3 - high performance liquid chromatography
4 - Serum protein electrophoresis and/or serum free light chains
4 - Serum protein electrophoresis and/or serum free light chains
- in MM the levels of these will be higher than normal
- the exact paraprotein can then be identified
- in the figure the patient would have an IgG Kappa para protein

A bone biopsy is often need for a definitive diagnosis of multiple myeloma (MM). What is the cut off for the % of nucleated cells in the bone marrow that need to be made up of monoclonal plasma cells for a diagnosis of MM to be made?
1 - >1%
2 - >10%
3 - >25%
4 - >45%
2 - >10%





